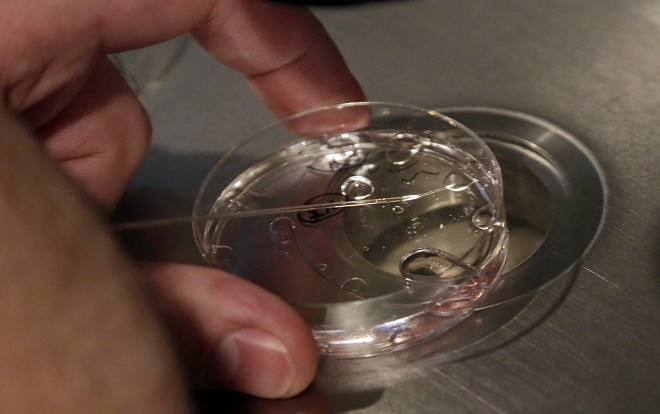
Nữ sinh bị dụ dỗ bán trứng bất hợp pháp với giá hơn 14.000 USD Ảnh 2

Các báo cáo cho biết một số bệnh viện đang giúp tiến hành các hoạt động bất hợp pháp để thu thập trứng phụ nữ. Ảnh: AP
Bất chấp luật pháp Trung Quốc nghiêm cấm buôn bán trứng người, nhu cầu từ những cặp vợ chồng không thể có con ở đất nước này vẫn rất cao nên tình trạng mua bán bất hợp pháp là không thể kiểm soát, tờ Thanh niên Bắc Kinh đưa tin.
Thành tích học tập, chiều cao và ngoại hình là ba đặc điểm đáng giá nhất. Những nữ sinh viên hội tụ đủ 3 yếu tố này sẽ được trả thêm tiền phí nhiều hơn giá bán ban đầu rất nhiều.
Thông thường một người đang cần tiền có thể ra giá khoảng 10.000 nhân dân tệ - nhưng một số cô gái vẫn sẵn sàng thực hiện thỏa thuận này chỉ để họ có thể mua điện thoại thông minh mới nên mức giá dao động tùy trường hợp.
Theo điều tra, các giao dịch bất hợp pháp thường được sắp xếp thông qua một đại lý, mặc dù một số cặp vợ chồng thích gặp trực tiếp người cho trứng. Các quán cà phê là nơi gặp gỡ ưa thích vì họ sẽ ít bị chú ý.
Theo như những gì một đại lý đại diện mua bán giữa đôi bên thì những thiếu sót và yếu kém về mặt thể chất sẽ là nguyên nhân chính dẫn đến vô sinh. Vì thế nên, việc mua bán trứng phụ nữ sẽ trở nên hợp pháp và chính đáng hơn.
Một số cặp vợ chồng muốn sinh con thứ hai sau khi Trung Quốc bãi bỏ chính sách một con, thì người vợ đã quá già để có thể sinh con một cách tự nhiên.
Báo cáo cho biết một số bệnh viện tư nhân đã thực hiện các thỏa thuận bí mật với đại lý để lấy trứng.
Các bệnh viện tiêm một lượng lớn hormone vào người hiến trong khoảng thời gian 10 ngày để tăng việc sản xuất trứng với tốc độ nhanh hơn nhiều lần so với bình thường. Sau đó, bệnh viện sẽ cho người hiến tặng thực hiện siêu âm và xét nghiệm máu để xác định khi nào có thể tiến hành phẫu thuật lấy trứng.

Một người hiến trứng đang được tiêm hormone liều cao để kích trứng. Ảnh: Alamy
Báo cáo cũng cảnh báo rằng có những rủi ro khi thực hiện thủ thuật, bao gồm các vấn đề về hô hấp, đầy hơi và hiện tượng đông máu trong các mạch máu.
Cho đến nay, không có một vụ bắt giữ chính thức nào được báo cáo trong những cuộc điều tra gần đây, nhưng vào năm 2016, hai đặc vụ đã bị bỏ tù vì lấy trứng từ một phụ nữ ở Quảng Châu, sau khi hiến trứng, người phụ nữ này đã phải cắt bỏ buồng trứng do biến chứng y khoa.
Hai tổ chức môi giới buôn bán trứng phụ nữ đã bị tuyên án tù lần lượt là 1 năm và 10 tháng vì hành nghề y tế mà không có giấy phép, theo Nam Metropolis News.
Theo luật pháp Trung Quốc, việc mua và bán trứng bị nghiêm cấm và chúng chỉ có thể được chấp nhận dưới dạng hiến tạng như một hành động từ thiện. Nhưng do nhu cầu cao đối với các dịch vụ thụ tinh trong ống nghiệm sau khi dỡ bỏ chính sách một con nên mới thúc đẩy thương mại bất hợp pháp.
Vào đầu năm nay, một cuộc điều tra của cổng thông tin Theapers.cn cho thấy các điều tra viên đang nhắm mục tiêu vào các sinh viên ở trung tâm thành phố Vũ Hán bằng cách đề nghị mua trứng của họ để thâm nhập sâu vào tổ chức mua bán này.